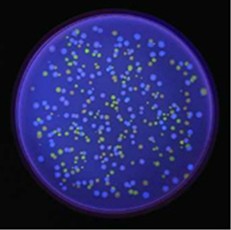
/gkimage/wd/9i/jr/wd9ijr.png

直到现在,“创世记”还是“创世纪”,依然让我迷惑。, h. ?( H! }! |
这个疑惑得追溯到我第一次看到有本书上赫然把西斯廷教堂穹顶画译为《创世纪》开始。《圣经》旧约的第一卷,是《创世记》,那么以此为主题的穹顶画名称应该是取其来源《创世记》呢,还是描述圣经故事的“创世——记”呢,还是更现代一点的“创——世纪”呢?(还没晕的同学请自行复读三遍)。眼下的情况是,中文的一律创世纪,英文的都是Genesis,至于翻译那就只能靠意会了。9 ]! `* `1 O6 c' }* D/ Y" M: \
创作者大抵都是有创世情节的,这里举三个Genesis例子:4 d3 A" y, g4 w; w, N
梵蒂冈西斯廷教堂穹顶,艺术家Michelangelo Buonarroti,1512年作品Genesis。
' i! m* m6 c6 _! u) {& ^奥地利林兹电子艺术节,艺术家Eduardo Kac,1999年作品Genesis。
" H; p# J* ]1 v" I) Z5 ?* ]首尔国际卡通动画节(SICAF),艺术家Ferenc Cako,2003年作品Genesis。, @8 ]0 }% X8 o/ i- v1 W1 S: {
/gkimage/3l/ld/h6/3lldh6.png
 对于意大利人、无比著名伟大的米开朗基罗,我偏执地认为西斯廷教堂的Genesis(见上图)带给他的更多是沉重。他兴趣本在雕塑,却不得不仰躺在脚手架上画了四年五个月五百多平米的穹顶画。无论老米在这穹顶之上创造的世界多么天才多么奇迹,但那过程中的苦痛与压抑却着实难以想象。后世的同名作品则不必背负这些,像这位被称为“遗传艺术家”的Eduardo Kac,以互动网络装置和“生物遗传艺术”(genetic art)获得了国际艺术界的高度推崇。他的Genesis是一个“转基因艺术”作品(见下图),探索了生物学、信仰体系、信息技术、互动对话、道德和网络之间错综复杂的关系。此作品的关键元素是“艺术家的基因”,一个由Kac设计出来的自然界中并不存在的基因,大致方法是将圣经《创世记》中的一句话转化成莫尔斯码,再根据艺术家专门为这个作品制定的转换规则将莫尔斯码变成DNA碱基对。被选择的文字为: “Let man have dominion over the fish of the sea, and over the fowl of the air, and over every living thing that moves upon the earth."这句话是影射关于神赋予的“人高于自然”这么一个模糊概念,至于引入莫尔斯码则是因为将其应用到极的无线电报出现意味着全球交流的开端。
对于意大利人、无比著名伟大的米开朗基罗,我偏执地认为西斯廷教堂的Genesis(见上图)带给他的更多是沉重。他兴趣本在雕塑,却不得不仰躺在脚手架上画了四年五个月五百多平米的穹顶画。无论老米在这穹顶之上创造的世界多么天才多么奇迹,但那过程中的苦痛与压抑却着实难以想象。后世的同名作品则不必背负这些,像这位被称为“遗传艺术家”的Eduardo Kac,以互动网络装置和“生物遗传艺术”(genetic art)获得了国际艺术界的高度推崇。他的Genesis是一个“转基因艺术”作品(见下图),探索了生物学、信仰体系、信息技术、互动对话、道德和网络之间错综复杂的关系。此作品的关键元素是“艺术家的基因”,一个由Kac设计出来的自然界中并不存在的基因,大致方法是将圣经《创世记》中的一句话转化成莫尔斯码,再根据艺术家专门为这个作品制定的转换规则将莫尔斯码变成DNA碱基对。被选择的文字为: “Let man have dominion over the fish of the sea, and over the fowl of the air, and over every living thing that moves upon the earth."这句话是影射关于神赋予的“人高于自然”这么一个模糊概念,至于引入莫尔斯码则是因为将其应用到极的无线电报出现意味着全球交流的开端。
* F5 ?% K$ ]) B
/gkimage/ax/0a/dg/ax0adg.png
 作品把人造基因克隆到细胞质体中,再将其移植给细菌,基因会产生一种新的蛋白质分子。作品中使用了两种细菌,加入了增强型青色荧光蛋白的细菌(ECFP)和加入了增强型黄色荧光蛋白的细菌(EYFP),只有青色细菌中含有人造基因。这两种细菌在紫外线的照射下会发出青色和黄色的荧光,部分细菌产生变异后逐渐互相接触,发生质体结合转移,直观表现为颜色合并,生成绿色荧光的细菌。伴随着细菌变异,青色细菌中携带的编码会发生变化,也就改变了选自《圣经》中的那句话。 _0 q" N& W* P- G
作品把人造基因克隆到细胞质体中,再将其移植给细菌,基因会产生一种新的蛋白质分子。作品中使用了两种细菌,加入了增强型青色荧光蛋白的细菌(ECFP)和加入了增强型黄色荧光蛋白的细菌(EYFP),只有青色细菌中含有人造基因。这两种细菌在紫外线的照射下会发出青色和黄色的荧光,部分细菌产生变异后逐渐互相接触,发生质体结合转移,直观表现为颜色合并,生成绿色荧光的细菌。伴随着细菌变异,青色细菌中携带的编码会发生变化,也就改变了选自《圣经》中的那句话。 _0 q" N& W* P- G
/gkimage/wd/9i/jr/wd9ijr.png
Eduardo Kac解释说,他想通过这个作品表达的意思是:“改变句子的能力是一个象征性的姿态:意味着我们并没有接受我们所继承形式中的意义,而当我们寻求改变的时候,新的意义就会出现。”# \5 s3 @% A4 { E2 X, P
Eduardo Kac解释说,他想通过这个作品表达的意思是:“改变句子的能力是一个象征性的姿态:意味着我们并没有接受我们所继承形式中的意义,而当我们寻求改变的时候,新的意义就会出现。”# \5 s3 @% A4 { E2 X, P
奥地利人Ferenc Cako是大师级的沙画艺术家,他采用新媒体艺术的形式来表现沙画的美妙,有评论说这种方式是“介于绘画和影像间的叙事姿态”。与米开朗基罗的沉重和Eduardo Kac的冷静都有所不同,Cako的Genesis是平和的,是温柔流动着的。有一段曾在网上广为流传的视频,虽然已非原作,但每看一遍都还是能感受到艺术所来的爱与感动。
& Q& V) D1 _: F4 i, H3 Z6 M5 b视频链接:http://v.youku.com/v_show/id_XMTMzOTc4ODgw.html/ {4 i3 n/ _5 { P l) E
Tips:1、 有人称西斯廷教堂穹顶画中暗藏着一副人脑解剖图,所谓米开朗基罗密码。
$ p5 {3 s! O* H9 H" }2、 Eduardo Kac另一转基因艺术作品是一只活着的兔子(见下图)——大名鼎鼎的绿色荧光兔。(恩,先不说改动生物存在形式带来的道德疑问,闪着绿光的兔子,看起来有点吓人呢!)/ _* ?8 C. ^/ d8 H4 I8 M3 P6 I
/gkimage/y1/tp/v3/y1tpv3.png
 3、 Ferenc Cako的Genesis,音乐是喜多郎的,选的真好啊真好。他还有部作品Story of the old castle,音乐也是喜多郎的,非常推荐。南通0
3、 Ferenc Cako的Genesis,音乐是喜多郎的,选的真好啊真好。他还有部作品Story of the old castle,音乐也是喜多郎的,非常推荐。南通0 |  苏公网安备 32060202000307号 © 2001-2019 0513.org All Right Reserved.
苏公网安备 32060202000307号 © 2001-2019 0513.org All Right Reserved.